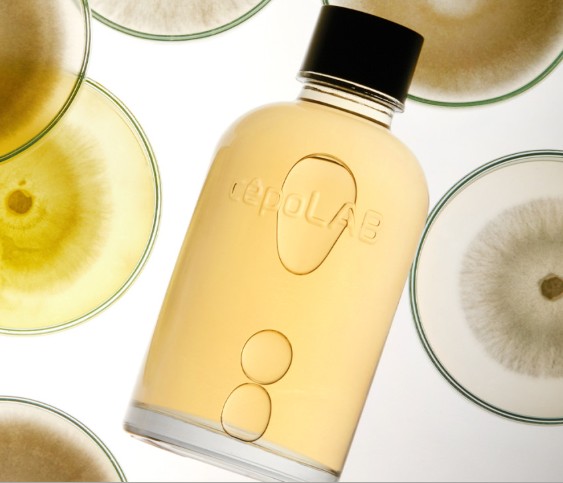
세포랩-바이오제닉-에센스-후기

요즘 다양한 스킨케어 트렌드가 등장하지만, “피부 바탕부터 다시 세운다”는 개념은 꾸준히 관심을 받고 있습니다. 특히 배우 김민하가 등장한 광고를 통해 화제가 된 세포랩 바이오제닉 에센스는 단순한 보습 에센스가 아니라 피부 스스로 힘을 키우는 데 집중한 제품이라는 점에서 주목받고 있습니다.
저 또한 여러 에센스를 사용해 보면서 이런 타입의 제품에는 유독 관심이 많았는데, 실제로 사용해보니 그 차별점이 확실해 세포랩 에센스에 대한 경험과 분석을 정리해보고자 합니다. 세포랩 바이오제닉 에센스의 핵심 성분, 실제 사용 후기, 효과적인 레이어링 방법까지 확인해보도록 하세요.
세포랩 바이오제닉 에센스, 무엇이 특별할까?
스킨케어 제품이 화려한 기능성 문구를 내세우는 것과 달리, 세포랩은 ‘피부의 에너지 회복’이라는 다소 깊이 있는 접근 방식을 택하고 있습니다.


세포랩 바이오제닉 에센스의 핵심은 클렙스(CLEPS™) 라는 독자 개발 원료입니다. 이 성분은 산소가 거의 없는 환경에서도 살아남는 미생물인 ‘세리포리아’를 연구해 얻어진 대사물질을 인공 배양하여 만든 신소재라고 알려져 있습니다.
즉, 단순히 피부 겉을 윤기 있게 만드는 것이 아닌, 피부가 지치고 예민해질 때 ‘스스로 회복할 힘’을 보충해 주는 데 초점을 맞춘 것이죠.
이런 개념이 꾸준한 관심을 받는 이유는, 특정 증상을 빠르게 가리는 방식의 스킨케어보다 피부 베이스 자체를 건강하게 만드는 접근이 더 오래 지속되기 때문입니다.
세포랩 에센스 92.8%의 주성분, 불필요한 성분을 최대한 배제한 심플한 구성
세포랩 바이오제닉 에센스를 손등에 떨어뜨렸을 때 가장 먼저 느껴지는 건 옅은 노란빛과 워터 타입 제형입니다.

이 컬러는 인공 색소가 아닌, 세리포리아 추출 과정을 거치며 자연스럽게 형성되는 색이라고 합니다. 전성분을 보면 정말 군더더기 없이 심플하고, 핵심 원료인 클렙스가 92.8%나 포함된 것을 확인할 수 있습니다.
많은 스킨케어 제품이 장식적인 성분을 나열하는 경우가 많지만, 이 제품은 정반대로 “불필요한 것은 최대한 덜고, 핵심 기능에 집중”했다는 점에서 신뢰도가 높았습니다. 특히 예민성 피부나 트러블이 잘 올라오는 타입이라면 이런 구성은 큰 장점이 됩니다.
가볍지만 힘 있는 제형, 빠른 흡수력
제형은 거의 물에 가까울 정도로 가볍습니다. 얼굴에 올리면 피부 결 사이로 바로 스며들며 끈적임이 없습니다.

향은 무향에 가까운데, 인위적인 향이 없는 대신 원료 고유의 은은한 자연향이 아주 약하게 남습니다. 이런 자연스러움은 오히려 제품에 대한 신뢰감을 높여주는 요소였습니다.
저는 스킨케어 첫 단계에서 3 회 레이어링으로 사용했는데, 무거움이 전혀 없어 여러 번 덧발라도 부담되지 않았습니다. 피부가 유독 칙칙하거나 피로가 쌓인 날에는 스킨–에센스–앰플 사이에 한 번 더 올려주면 피부가 확실히 안정되는 느낌이 들었습니다.
며칠 후 느껴지는 피부 ‘바탕 변화’


세포랩 에센스의 가장 큰 강점은 즉각적인 광택이 아닌 누적형 개선이었습니다. 사용 며칠 후부터 피부가 다음과 같이 조금씩 달라지는 것이 느껴졌습니다.
- 속건조 완화
- 거칠었던 피부결 정돈
- 피지·모공 흐트러짐 개선
- 유분·수분 밸런스 균형
- 메이크업 밀착도 향상
무엇보다 메이크업을 했을 때 베이스가 더 자연스럽게 밀착되면서 피부 표면이 ‘잔잔하게 정돈된 느낌’을 주는 변화가 인상적이었습니다.
화려하게 광을 내는 제품들이 많은데, 세포랩 바이오제닉 에센스는 그런 인위적인 윤기보다 속에서 올라오는 자연스러운 생기에 더 가까운 결과를 보여주었습니다.
환경을 고려한 패키징, 디테일까지 담긴 브랜드 철학
요즘 스킨케어 브랜드들은 지속 가능성을 중요하게 생각하는데, 세포랩 에센스 역시 이를 실천하고 있습니다.
박스를 제거하고 불필요한 인쇄를 뺀 투명 미니멀 패키징을 채택해 재활용성을 높였습니다. 실제로 받아보면 군더더기 없는 감각적인 디자인이 제품의 콘셉트와도 잘 어울립니다.
세포랩 바이오제닉 에센스 후기 살펴보기

대표적인 세포랩 바이오제닉 에센스 후기를 인터넷을 통해 찾아본 결과 다음과 같은 긍정적인 후기들을 찾아볼수 있는데요. 참고하시면 도움이 될 것입니다.
- 가볍게 스며드는 워터 타입으로 초기 속보습과 흡수력이 특히 좋다.
- 2주차부터 피부결이 매끈해지고 메이크업 밀착력이 높아진다.
- 3주차에는 예민도·피지 균형이 안정되며 피부 컨디션이 흔들리는 날 도움된다.
- 4주차부터 자연스러운 윤기와 건강한 피부 바탕 변화가 가장 확실하게 느껴진다.
세포랩 사용 팁 요약(효과 UP)
- 세안 직후 가장 먼저 2~3회 레이어링
- 흡수는 자연스럽게, 강하게 두드릴 필요 없음
- 피부 컨디션이 떨어진 날은 단계 사이사이에 중간 레이어링
- 화장솜에 적셔 5분 수분 팩으로 사용하면 텍스처 정돈 효과 상승
2025.11.03 - [건강스토리] - 고혼진 화장품 가격(기미크림가격) 4개월 사용 후기
고혼진 화장품 가격(기미크림가격) 4개월 사용 후기
40대 중반이 넘어가니 정말 피부가 예전 같지 않다는 걸 실감해요. 아침마다 거울을 보면 전에는 잘 안 보이던 기미가 점점 진해지고, 웃을 때마다 눈가 주름이 또렷하게 보이더라고요. 그동안
wikinote.inforank.net
특히 화장솜 팩은 다음 날 피부결과 메이크업 표현에서 차이가 크게 느껴져, 중요한 일정이 있는 날 자주 사용하는 방법입니다.
피부 본연의 힘을 회복하고 싶은 사람에게 딱 맞는 첫 단계 에센스
세포랩 바이오제닉 에센스는 단순히 촉촉함을 채우는 제품이 아니라, 피부의 근본적인 컨디션을 되살리는 데 도움을 준다는 점에서 의미가 큽니다. 예민함이 반복되거나, 메이크업이 잘 먹지 않거나, 피부가 전체적으로 지쳐 보이는 시기에 특히 추천하고 싶은 첫 단계 에센스입니다.
기능성 문구보다 실제 피부 변화로 신뢰를 얻는 제품을 찾고 있다면 세포랩 에센스는 분명 만족도가 높은 선택이 될 것입니다.
